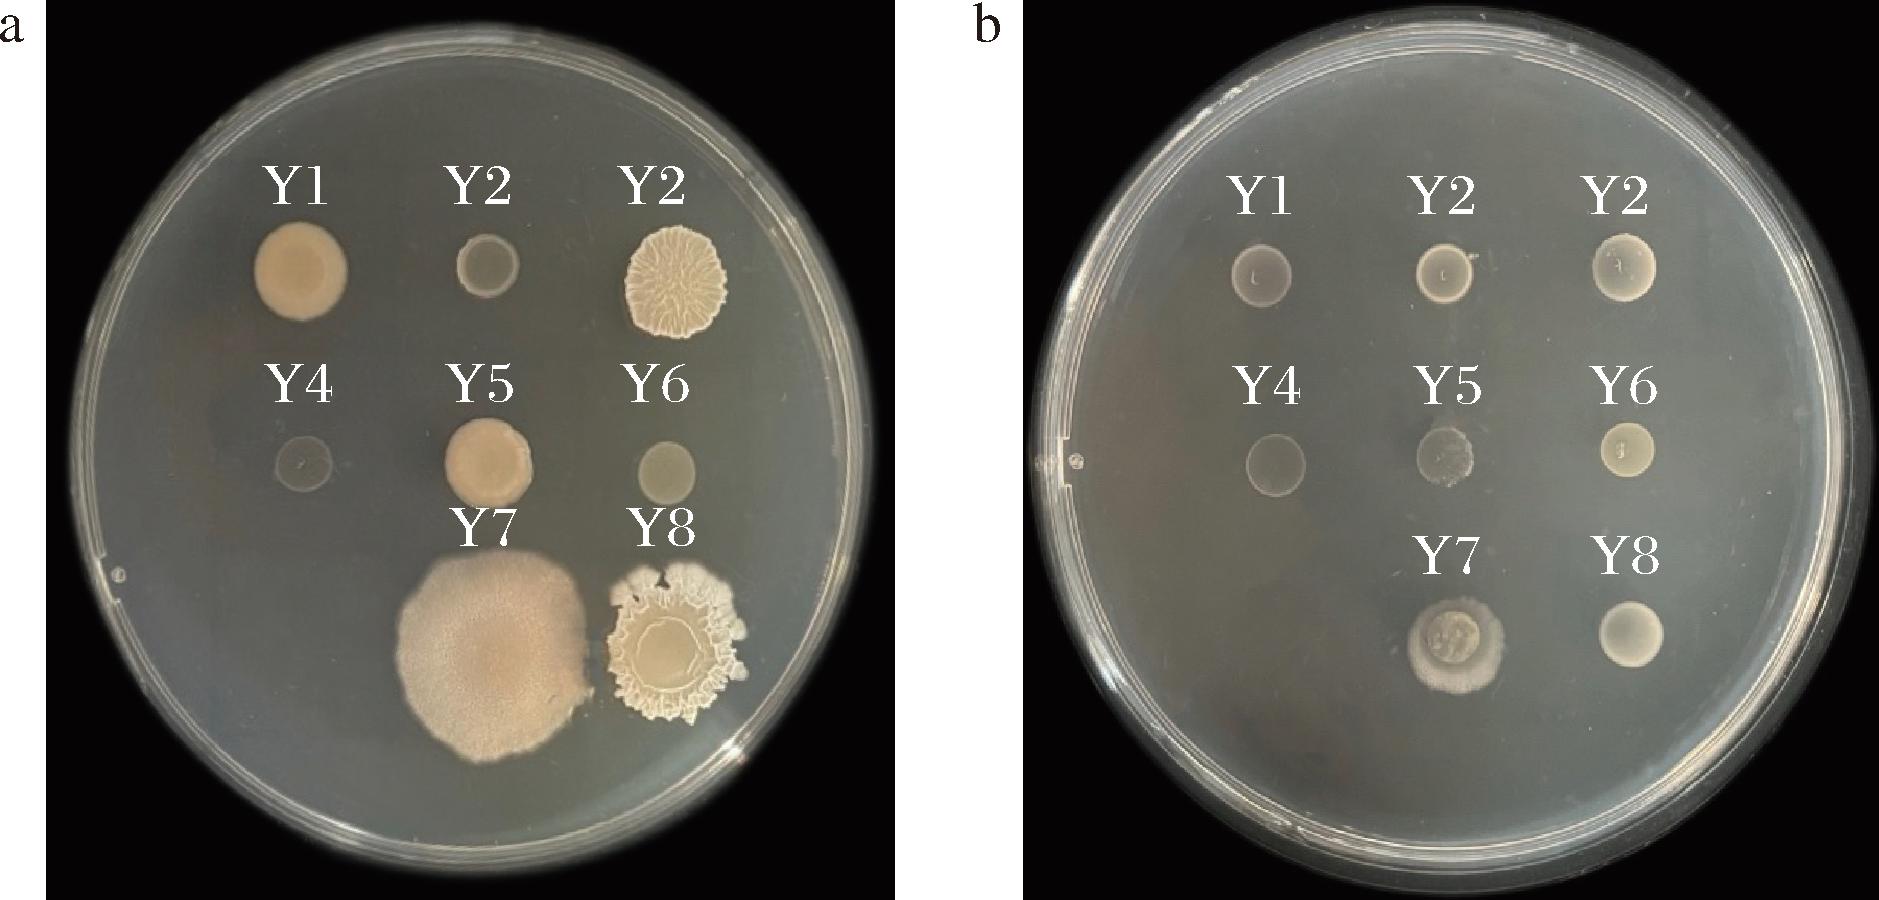
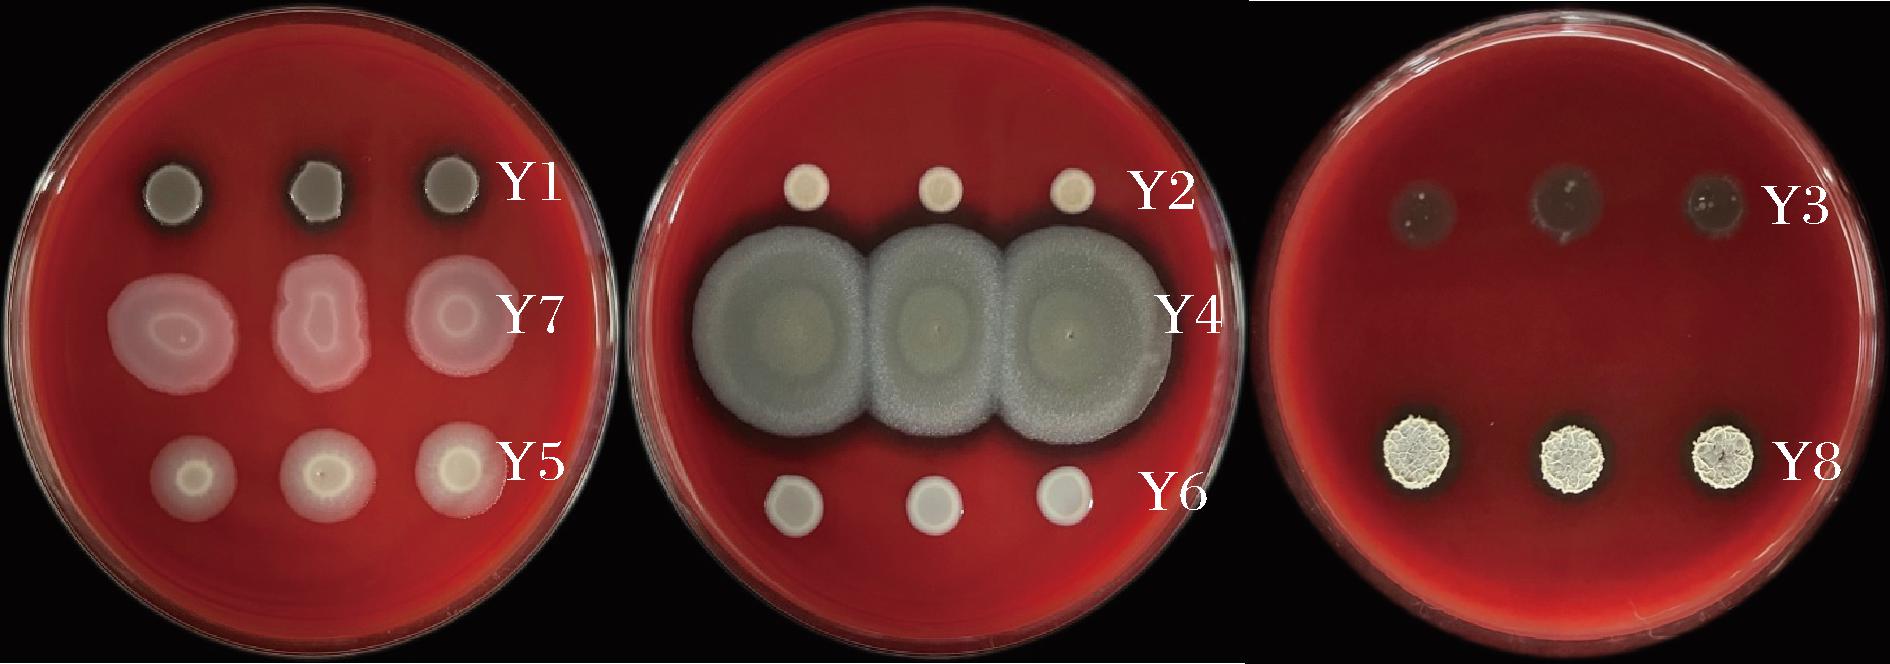

兰州百合[Lilium davidii var.willmottiae(E.H.Wilson)Raffill]是川百合属中的一个变种,属多年生宿根草本植物[1]。兰州百合作为享誉国内外的名优特色药食同源蔬菜,其鳞茎表皮脆弱、水分含量较高且营养丰富。在采挖和贮藏过程中,易导致呼吸加速和乙烯生成增多,进而引起鳞茎衰老、变色和腐烂等问题,对食品安全产生严重影响,并阻碍了兰州百合产业的健康发展[2]。因此,寻找一种天然、高效、环保、经济的采后贮藏保鲜方法对于延长兰州百合的保鲜期和提高其商品性具有重要意义。
1-氨基环丙烷-1-羧酸(1-aminocyclopropane-1-carboxylic acid,ACC)是植物内源乙烯合成的前体,当植物遭受环境刺激时,会合成大量乙烯,从而促进植物衰老和腐烂变质[3]。研究表明,土壤中的部分根际菌能够合成1-氨基环丙烷-1-羧酸脱氨酶(1-aminocyclopropane-1-carboxylic acid deaminase,ACCD),将乙烯的前体物质ACC分解为氨和α-丁酮酸,从而降低植物内乙烯水平,延缓植物衰老[4]。ALI等[5]采用荧光假单胞菌YsS6来延缓康乃馨切花的衰老。然而,由于环境条件对菌株和酶产生较大影响,通常采用包埋技术制备各种剂型以提高化学稳定性并扩大应用范围[6]。赵群等[7]利用海藻酸钠/聚乙烯醇复合固定醋酸菌,增强了醋酸菌的产酸量和产酸稳定性。伍悦等[8]采用阿拉伯木聚糖和海藻酸钠复合包埋植物乳植杆菌,有效改善了植物乳植杆菌的储藏稳定性。然而目前有关ACCD活性菌株包埋技术的研究较少,尤其在果蔬保鲜领域。因此,本研究以海藻酸钠(sodium alginate,SA)和玉米醇溶蛋白(Zein)为基材对分离筛选出的安全且具有较高ACCD活性的菌株进行包埋,制备出一种复合涂膜剂并进行工艺优化。同时,通过扫描电子显微镜(scanning electron microscope,SEM)、傅里叶变换红外光谱(Fourier transform infrared spectroscopy,FT-IR)、X射线衍射(X-ray diffraction,XRD)等方法表征膜剂的形态、特性并评价其在不同温度下对兰州百合的保鲜效果,以期为研究兰州百合保鲜的新技术提供科学依据。
1 材料与方法
1.1 材料与试剂
兰州百合,兰州甜甜百合有限公司。试验菌株(表1)均来自于兰州百合根际土壤,并保存于本实验室。
表1 供试菌株
Table 1 The strains tested

菌株名称相似性/%GenBank登录号Y1荧光假单胞菌Pseudomonas fluorescens strain W-6100MF949058.1Y2红平红球菌Rhodococcus erythropolis strain FF999.93JQ435727.1Y3解淀粉芽孢杆菌Bacillus amyloliquefaciens strain MEG1100MH265992.1Y4蜡样芽孢杆菌Bacillus cereus strain ZLynn1 000-13100KY316447.1Y5冷孢杆菌Peribacillus frigoritolerans strain XM21 100MT023397.1Y6氧化微杆菌Microbacterium oxydans strain MV-PHGII-2100KP136284.1Y7枯草芽孢杆菌Bacillus subtilis strain Z57100OR121784.1Y8贝莱斯芽孢杆菌Bacillus velezensis strain J-1 100MW829522.1
SA、Zein、甘油(glycerol,Gl)均为分析纯,天津百伦斯生物技术有限公司;α-丁酮酸、2,4-二硝基苯肼、CaCl2均为分析纯,国药集团试剂有限公司;DF、ADF和胰酪大豆胨(tryptic soy broth,TSB)培养基,北京 Coolaber 公司;哥伦比亚血琼脂平板,环凯生物技术有限公司;丙二醛(malondialdehyde,MDA)含量、过氧化物酶(peroxidase,POD)、多苯丙氨酸解氨酶(phenylalanine ammonia lyase,PAL)试剂盒,北京盒子生工科技有限公司。
1.2 仪器与设备
BioTek-Gen5酶标仪,美国Thermo Fisher公司;ULTRA plus扫描电镜,德国Zeiss公司;UV 2800紫外可见分光光度计,上海甬能有限公司;ALPHA II傅立叶变换红外光谱仪,德国Bruker公司;Ultima IV X射线衍射仪,日本理学株式会社;ZD-88全温振荡器,常州金坛恒丰有限公司。
1.3 实验方法
1.3.1 ACCD活性菌株的筛选
参照PENROSE等[9]的方法将菌株分别接种至DF和ADF培养基上,28 ℃培养3~5 d,经3次传代培养后,若菌株能在ADF培养基上生长,说明该菌株能够降解ACC,即该菌株可以合成ACCD。
1.3.2 菌株形态结构观察
在TSB平板培养基上进行划线培养,28 ℃培养24 h,记录菌落形态[10]。
1.3.3 ACCD活性的测定
采用李明源等[11]的方法测定ACCD活性并稍作改进。将菌体经过DF液洗涤后重悬于ADF中培养24 h,再取菌液离心10 min,弃上清液,收集并测定菌体质量。采用2,4-二硝基苯肼比色法测定。ACCD活性以μmol/(mg·h)为单位,即1 mg的酶蛋白1 h之内产生α-丁酮酸的物质的量。
1.3.4 菌株溶血性测定
取5 μL 菌液接种于血红平板上,每个平板以相等的间距设置3个重复,28 ℃下培养24 h,观察菌落四周有无透明的溶血圈[10]。
1.3.5 涂膜剂的制备流程
Zein溶液的制备:取0.3 g Zein溶解于5 mL体积分数为60%乙醇溶液中;SA溶液的制备:取一定SA溶解于80 ℃水中。CaCl2溶液的制备:取一定的CaCl2溶解于水中,灭菌并冷却。
将Zein溶液和SA溶液混合后,添加甘油,600 r/min磁力搅拌10 min,获得载体液。将该液于120 ℃灭菌冷却后以体积比2∶1加入OD600值为0.8左右的菌液,再滴入CaCl2溶液中固定5 min,制得涂膜剂。
1.3.6 涂膜剂包埋率的测定
取1 g涂膜剂放入无菌试管中,加入2 mL 0.2 mol/L NaHCO3和8 mL 0.06 mol/L柠檬酸三钠溶液,于28 ℃、180 r/min的振荡器中解崩后,吸取1 mL试样在平板上稀释涂布,并按公式(1)计算膜剂中菌株的包埋率[12]。
包埋率/%=(涂膜剂包埋菌量/总菌量)×100
(1)
1.3.7 单因素对菌株包埋率及ACCD活性的影响
参照凌晓冬等[13]的方法分别对SA质量分数、Gl添加量和CaCl2溶液质量分数3个单因素进行考察,分析各因素对涂膜剂菌株包埋率及ACCD活性的影响规律。条件分别是SA质量分数:2%、4%、6%、8%;Gl添加量:10%、20%、30%、40%,均为体积分数;CaCl2质量分数:0%、1%、3%、5%。
1.3.8 涂膜剂制备工艺优化
综合单因素试验结果,以包埋率(Y)为响应值,对主要因素SA质量分数(A)、Gl添加量(B)和CaCl2质量分数(C)进行响应面优化。因素及水平的设计如表2所示,采用Design-Expert软件进行回归模型分析。
表2 响应面法分析因素及水平
Table 2 Factors and levels of response surface experiment

水平因素A(SA质量分数)/%B(Gl添加量)/%C(CaCl2质量分数)/%-121010420316305
1.3.9 涂膜剂的结构分析
1.3.9.1 SEM测定
使用SEM(10 kV)观察SA、Zein和涂膜剂的超微结构。
1.3.9.2 FT-IR分析
通过FT-IR分析SA、Zein和涂膜剂的化学结构的变化,扫描范围4 000~400 cm-1,分辨率2 cm-1。
1.3.9.3 XRD分析
利用XRD对SA、Zein、涂膜剂进行分析。测试条件为:配置射线源Cu Kα(40 kV,40 mA),扫描角度(2θ)为5°~60°,扫描速度约2°/min。
1.3.10 涂膜剂在兰州百合保鲜中的应用
1.3.10.1 样品处理
将大小相似的兰州百合鳞茎片用有效氯浓度为5%NaClO浸泡10 min,采用无菌水洗净晾干后,随机分成3组。1)将鳞茎片在无菌水浸泡8 min,用T1表示。2)将鳞茎片浸入菌液8 min,用T2表示。3)将鳞茎片先在膜液中浸泡3 min,再在2.8% CaCl2溶液中浸泡5 min成膜,用T3表示。每项试验共进行3次重复。以上3种处理进行自然干燥后,再于相对湿度55%下贮藏15 d。设置低温(4 ℃)、室温(20 ℃)2个处理组,并每隔3 d测定一次有关指标。
1.3.10.2 涂膜剂对兰州百合褐变度和呼吸速率的影响
褐变度采用比色法[14]测定;呼吸速率采用静置法[15]测定。
1.3.10.3 涂膜剂对兰州百合MDA含量和相关酶活性的影响
分别采用MDA含量、POD和PAL试剂盒测定,操作步骤详见对应的说明书。
1.3.11 数据处理
每个试验组做3次重复试验,试验结果采用SPSS 22.0进行显著性差异分析(显著水平P<0.05),运用Design-Expert 13进行响应面分析,并使用GraphPad Prism 8绘制图表。
2 结果与分析
2.1 ACCD活性菌株的筛选
图1中观察到各菌株连续3次传代培养后均能在ADF培养基上生长,说明这8种菌株均能合成ACCD。其中,Y6菌株在ADF培养基中的生长效果优于DF培养基,初步表明Y6菌株合成ACCD的能力较高。
a-DF培养基;b-ADF培养基
图1 ACCD活性菌株定性筛选
Fig.1 Qualitative screening of ACCD active strains
2.2 菌株形态特征及ACCD活性
从表3中发现,这些菌株的菌落形态大多为圆形,呈白色系,部分菌落表面水润圆滑,而其他则较为干燥。经定量分析发现,Y6在所有菌株中酶活性最高,达到(0.119±0.006) μmol/(mg·h),而Y7酶活性最低。Y6的酶活性约为Y7的4.41倍。
表3 各菌株菌落形态特征及ACCD活性
Table 3 Colony morphological characteristics and ACCD activity of each strain

菌株编号菌株形态ACCD活性/[μmol/(mg·h)]Y1圆形,透明色,饱满,隆起,表面水润0.038±0.003cY2圆形,珍珠白色,饱满,隆起,表面水润0.033±0.001cdY3圆形,米白色,饱满,凹凸不平,表面较干燥0.032±0.002dY4圆形,浅白色,饱满,扁平,表面较水润0.038±0.001cY5圆形,象牙白色,饱满,隆起,表面水润0.036±0.003cdY6圆形,亮黄色,饱满,隆起,表面水润0.119±0.006aY7圆形,乳白色,饱满,扁平,表面较干燥0.027±0.002eY8不规则,纯白色,不饱满,凹凸不平,表面干燥0.054±0.002b
注:不同小写字母表示存在显著差异 (P<0.05)。
2.3 溶血试验
图2中观察到Y1、Y3、Y4和Y8菌落周围出现明显的溶血透明圈,表明它们具有溶血效果;而其余菌株的菌落则无,说明这些菌株不具备溶血能力,安全性较好。因此,综合考虑采用Y6进行后续制膜试验。
图2 各菌株的溶血性检测
Fig.2 Hemolysis test plate of each strain
2.4 单因素试验
根据图3可知SA质量分数、Gl添加量和CaCl2质量分数均对菌株包埋率及ACCD活性有影响。可能是SA质量分数增加有利于SA与Zein产生静电作用,形成致密的网络结构,但SA较高时,结构过于紧密,使磁力搅拌效果变差,进而影响包埋效率[16]。其次,甘油能增强蛋白质分子间的氢键作用,提高包埋效率[13]。但过量的甘油吸水性较强,减弱了分子间相互作用力,使聚合物分子之间空隙率上升,导致包埋物大量流失,从而降低包埋效果[17]。CaCl2为常用的交联剂,能与SA形成稳定的三维立体结构[18]。随着CaCl2质量分数的增加,交联度越强,然而较高CaCl2质量分数会使膜剂的通透性降低,从而致使包埋效果变差[19]。

a-SA质量分数;b-Gl添加量;c-CaCl2质量分数
图3 单因素对菌株包埋率及ACCD活性的影响
Fig.3 Effects of single factor on strain embedding rate and ACCD activity
2.5 响应面和方差分析结果
由表4、表5可知,根据上述试验结果分析,得到自变量与包埋率(Y)的回归方程为:Y=58.19-6.01A+9.89B-6.03C-3.58AB-6.01AC-0.32BC-10.1A2-20.33B2-18.55C2。
表4 响应面试验结果
Table 4 Results of response surface experiment

编号ABCY(包埋率)/%编号ABCY(包埋率)/%1-11051.29100-117.06201122.571100057.34300055.511201-132.20410-139.361300063.95511027.621410112.20600054.59150-1-115.417-1-1020.7416-10-134.87800059.5517-10131.7591-1011.38
表5 回归方程的方差分析
Table 5 Analysis of variance (ANOVA) of regression equations

方差来源平方和自由度均方F值P值显著性模型浓度5 559.839617.7630.58<0.000 1∗∗A 海藻酸钠质量分数289.081289.0814.310.006 9∗∗B 甘油添加量781.91781.938.70.000 4∗∗C CaCl2质量分数291.131291.1314.410.006 7∗∗AB51.19151.192.530.155 4AC144.481144.487.150.031 8∗BC0.409 610.409 60.020 30.890 8A2429.321429.3221.250.002 5∗∗B21 740.7211 740.7286.17<0.000 1∗∗C21 448.1111 448.1171.68<0.000 1∗∗残差141.41720.2失拟项85.52328.512.040.250 9纯误差55.89413.9730.58总差5 701.2416
注:*表示影响显著(P<0.05);**表示影响极显著(P<0.01)。
由表5可知,该模型的P值<0.01,差异极显著,失拟项P值=0.250 9(P>0.05),不显著,R2和![]() 分别为0.975 2和0.943 3,综合说明该模型和试验数据拟合良好。且该模型回归方程的置信度高,误差小,可用于对菌株包埋率进行预测。
分别为0.975 2和0.943 3,综合说明该模型和试验数据拟合良好。且该模型回归方程的置信度高,误差小,可用于对菌株包埋率进行预测。
2.6 响应面图分析
从图4 各因素对菌株包埋率的影响可以看出,SA质量分数和CaCl2质量分数之间交互作用较强,而Gl添加量和CaCl2质量分数之间交互作用较弱;Gl添加量较于SA质量分数和CaCl2质量分数对包埋率的影响程度高,且SA质量分数对包埋率影响优于CaCl2质量分数,说明Gl添加量和SA质量分数是影响涂膜剂的主要因素。

a-SA质量分数和Gl添加量;b-SA质量分数和CaCl2质量分数;c-Gl添加量和CaCl2质量分数
图4 各因素对菌株包埋率的影响
Fig.4 Effects of various factors on the embedding rate of strains
2.7 验证试验
通过Design-Expert 13推荐菌株包埋率的预测值为60.81%。考虑到实际应用中的可操作性,对响应面修正得到最佳工艺为:SA质量分数3.4%、Gl添加量22.8%、CaCl2质量分数2.8%,经过3次重复试验,得到Y的平均值为60.56%。与预测值相比偏差小,模型可靠。
2.8 涂膜剂的SEM形貌
由图5-a和图5-b可知,单独的SA和Zein呈无规则颗粒状且分散均匀。但两者制成涂膜剂后,其SEM形貌发生了显著变化,出现了异质结构。如图5-c所示,可以看到膜的表面较为致密紧凑且存在折叠和折痕,这可能是固化过程中膜表面结构发生脱水收缩效应所致[20],而在膜的断面则表现为疏松多孔。在放大2 000倍的电镜下对断面部分进一步地观察发现,其内部呈现典型的蜂窝状网络结构(图5-d)。该结构为涂膜剂储存生物活性成分提供了充足空间,并对包封的成分有更好的保护作用[21]。

a-SA;b-Zein;c-涂膜剂表面及断面;d-涂膜剂断面
图5 SA、Zein和涂膜剂的微观形貌
Fig.5 SEM images of SA, Zein and coating agent
2.9 涂膜剂FT-IR和XRD分析
图6-a为SA、Zein和涂膜剂的FT-IR谱图。与SA和Zein的相比,涂膜剂的O—H特征吸收峰变宽且向蓝移,氢键增加[22];1 629 cm-1为Zein的酰胺I带特征峰,涂膜剂中相应峰迁移至1 645 cm-1,说明Zein和SA的结合过程可能存在疏水效应[23];1 417 cm-1处的峰,为SA的COO—伸缩振动吸收峰,而在涂膜剂中显示该峰红移,可知SA已成功包裹到Zein上[24]。综上可知,红外光谱的特征吸收峰与涂膜剂的组成变化之间形成了良好的印证关系,增强了涂膜剂的稳定性、网状致密性。

a-FT-IR;b-XRD
图6 涂膜剂的 FT-IR与XRD谱图
Fig.6 FTIR and XRD spectrum patterns of coating agent
图6-b为SA、Zein和涂膜剂的XRD谱图。图中SA和Zein弱峰和尖峰分别在13.49°、9.12°、20.37°和19.8°处出现。而2种基材制备成涂膜剂后,SA和Zein的弱峰逐渐消失并在21.94°左右出现宽峰,说明2种基材之间可进行某种程度的相容,产生氢键,从而使膜剂结构更稳定[25]。
2.10 涂膜剂对兰州百合褐变度和呼吸速率的影响
如图7-c和图7-d所示,2组兰州百合的褐变度均呈现上升趋势。常温中T1组褐变度增加最快,15 d时已达到9.13±0.2,为T3组的2.12倍。而低温T3组贮藏15 d后,褐变度为3.82±0.05,是常温T3组的0.89倍。此外,随着贮藏期的延长,2个温度下的兰州百合鳞茎片颜色会从明亮干净的白色逐渐褐化到紫红色(图7-a和图7-b)。T1组的鳞茎片均在第3天开始变褐,T2组的鳞茎片分别在第6和第9天开始变褐,而T3组仅在12 d出现轻微褐变。结果表明,涂膜处理能有效延缓兰州百合鳞茎片的褐变进程,抑制了百合的褐变度,并在室温下表现出了更好的抑制效果。

a-常温下百合的外观品质;b-低温下百合的外观品质;c-常温下百合的褐变度;d-低温下百合的褐变度;e-常温下百合的呼吸速率;f-低温下百合的呼吸速率
图7 涂膜剂对兰州百合外观品质、褐变度和呼吸速率的影响
Fig.7 Effects of coating agent on appearance, browning degree and respiration rate of Lanzhou lily
图7-e和图7-f显示,T3组的呼吸强度在整个贮藏期均显著低于T1组(P<0.05)。常温下,T1和T2组在第12天出现呼吸高峰,其峰值分别为107.59 mg/(kg·h)和68.03 mg/(kg·h);而低温下仅有T1组出现了72.82 mg/(kg·h)呼吸高峰。可能是涂膜剂的致密性,减少了O2渗透率来抑制百合的代谢速率,创造出低氧和高二氧化碳环境来抑制兰州百合的代谢速率[26];另一方面可能是ACC得到了降解,乙烯生成量降低,抑制了兰州百合的呼吸速率[27]。这表明涂膜处理能延缓兰州百合衰老,降低其呼吸作用并推迟呼吸高峰的出现。
2.11 涂膜剂对兰州百合MDA含量和相关酶活性的影响
如图8-a和图8-b显示,百合贮藏期间PAL活性呈先上升后下降的趋势。乙烯诱导了PAL合成,从而增加了PAL活性[28]。随着时间延长,由于PAL活性可以通过其产物的反馈抑制来调节,PAL活性逐渐减弱[28]。贮藏15 d后,低温下T1、T2和T3组的PAL活性分别为(3.65±0.33)、(3.14±0.13)、(2.53±0.15) U/g,分别为常温组的77%、98%、96%,表明低温和涂膜剂的复合使用可以抑制百合鳞茎片中的PAL活性和酚类物质积累,减缓其衰老。

a-常温下百合的PAL活性;b-低温下百合的PAL活性;c-常温下百合的POD活性;d-低温下百合的POD活性;e-常温下百合的MDA含量;f-低温下百合的MDA含量
图8 涂膜剂对兰州百合PAL活性、POD活性和MDA含量的影响
Fig.8 Effects of coating agent on PAL activity, POD activity and MDA content of Lanzhou Lily
图8-c中T1和T2组POD活力呈先增后减的趋势,而T3组POD活性则缓慢上升且低于T1和T2组(P<0.05),表明涂膜处理能抑制百合中POD的增加,并减少其褐变。其次,在图8-d中,T1、T2和T3组的POD活性均呈增长趋势。15 d时,分别达到(197.0±14.36)、(159.23±9.11)、(97.15±7.21) U/g。其中,T1组POD的活性较高,表明冷藏期T1组细胞损害的加剧,与上述低温T1组褐变规律一致。综上说明涂膜处理能降低百合中POD活性并抑制兰州百合的褐变。梁仕茹等[29]在圣女果相关研究中报道类似结果。
由图8-e和图8-f显示,在贮藏期,各处理组MDA含量均升高。且贮藏15 d后,T1和T2组的MDA含量均显著高于T3组(P<0.05)。与初始含量相比,低温下T1、T2和T3组的增长率分别为163.83%、155.81%和85.05%,相对于常温增长率较低。这说明低温和涂膜处理能减缓兰州百合在贮藏过程中细胞膜的损伤,并抑制其衰老。
3 结论与讨论
本研究分离筛选出安全性好且ACCD活性较高的M.oxydans MV-PHGII-2并用包埋技术制备出一种复合涂膜剂。经过工艺优化后得到的膜剂最佳工艺条件为:SA质量分数3.4%,Gl添加量22.8%,CaCl2质量分数2.8%。在此工艺条件下,菌株的包埋率为60.56%,有效改善了菌株及其ACCD的化学稳定性。通过对膜剂的结构和性能研究发现,该膜剂呈现典型的蜂窝状网络结构,并且各组分之间产生相互作用力,其结构稳定性好。随后,在不同温度下使用制备的涂膜剂对兰州百合进行保鲜处理,结果显示,与未涂膜组相比,涂膜处理能显着降低有效降低兰州百合鳞茎片的褐变度、减缓呼吸速率和MDA含量、并抑制POD和PAL的活性,延缓衰老进程,在同处理条件下的4 ℃具有较优的贮藏效果。综合多项指标测试结果得知将低温与润色材料复配使用也能够延缓兰州百合衰老进程并维持采摘后品质稳定。
[1] LI X, ZHANG C Y, WANG X Q, et al.Integration of metabolome and transcriptome profiling reveals the effect of modified atmosphere packaging (MAP) on the browning of fresh-cut Lanzhou lily (Lilium davidii var.unicolor) bulbs during storage[J].Foods, 2023, 12(6):1335.
[2] ZHANG H S, WU X T, LIU X J, et al.Hydrogen gas improves the postharvest quality of Lanzhou lily (Lilium davidii var.unicolor) bulbs[J].Plants, 2023, 12(4):946.
[3] VAN DE POEL B, VAN DER STRAETEN D.1-aminocyclopropane-1-carboxylic acid (ACC) in plants:More than just the precursor of ethylene![J].Frontiers in Plant Science, 2014, 5:640.
[4] SINGH R P, PANDEY D M, JHA P N, et al.ACC deaminase producing rhizobacterium Enterobacter cloacae ZNP-4 enhance abiotic stress tolerance in wheat plant[J].PLoS One, 2022, 17(5):e0267127.
[5] ALI S, CHARLES T C, GLICK B R.Delay of flower senescence by bacterial endophytes expressing 1-aminocyclopropane-1-carboxylate deaminase[J].Journal of Applied Microbiology, 2012, 113(5):1139-1144.
[6] LI Q Y, LIU M L, LIU M J, et al.Preparation, characterization and in vitro digestion of jujube polysaccharide microcapsules[J].Food and Bioproducts Processing, 2024, 145:97-104.
[7] 赵群, 李静, 窦召语, 等.海藻酸钠-聚乙烯醇复合固定醋酸菌研究[J].中国调味品, 2019, 44(12):35-38.ZHAO Q, LI J, DOU Z Y, et al.Study on the immobilization of acetic acid bacteria with sodium alginate and polyvinyl alcohol[J].China Condiment, 2019, 44(12):35-38.
[8] 伍悦, 张根义, 彭善丽.阿拉伯木聚糖和海藻酸钠复合包埋益生菌研究[J].食品与生物技术学报, 2018, 37(8):868-874.WU Y, ZHANG G Y, PENG S L.Survival of arabinoxylans-alginate microencapsulated probiotics[J].Journal of Food Science and Biotechnology, 2018, 37(8):868-874.
[9] PENROSE D M, GLICK B R.Methods for isolating and characterizing ACC deaminase-containing plant growth-promoting rhizobacteria[J].Physiologia Plantarum, 2003, 118(1):10-15.
[10] 罗成莹, 何秀, 徐美余, 等.五株乳酸菌和三株芽孢杆菌的生物学特性和功能[J].微生物学通报, 2024, 51(1):172-188.LUO C Y, HE X, XU M Y, et al.Biological properties and functions of five strains of lactic acid bacteria and three strains of Bacillus[J].Microbiology China, 2024, 51(1):172-188.
[11] 李明源, 王继莲, 姚拓, 等.产ACC脱氨酶细菌的筛选及对低温胁迫下垂穗披碱草生长的影响[J].草原与草坪, 2022, 42(5):37-45.LI M Y, WANG J L, YAO T, et al.Screening of ACC deaminase producing bacteria and their effects on the growth of Elymus nutans under low-temperature stress[J].Grassland and Turf, 2022, 42(5):37-45.
[12] 王召, 尹明明, 陈福良.阿维菌素B2海藻酸钠-壳聚糖包埋颗粒剂的制备及性能研究[J].农药学学报, 2017, 19(6):744-754.WANG Z, YIN M M, CHEN F L.Abamectin B2-loaded alginate-chitosan embedding granules:Preparation and characteristics[J].Chinese Journal of Pesticide Science, 2017, 19(6):744-754.
[13] 凌晓冬, 张良, 戴一朋, 等.海藻酸钠-小麦醇溶蛋白复合膜的研制[J].美食研究, 2021, 38(2):84-88.LING X D, ZHANG L, DAI Y P, et al.Study on preparation of sodium alginate-gliadin composite film[J].Journal of Researches on Dietetic Science and Culture, 2021, 38(2):84-88.
[14] 巩慧玲, 李飞, 孙爱洁, 等.纳他霉素壳聚糖复合涂膜对兰州百合鳞茎片的保鲜效果[J].食品与发酵工业, 2016, 42(2):208-212.GONG H L, LI F, SUN A J, et al.Effects of natamycin and chitosan coating compounds on freshkeeping of Lanzhou lily bulb during storage[J].Food and Fermentation Industries, 2016, 42(2):208-212.
[15] 缪嘉琪, 蔡寅川, 章彦楷, 等.月桂酰精氨酸乙酯-壳聚糖涂膜对车厘子保鲜效果及保鲜机理的研究[J].食品与发酵科技, 2022, 58(5):19-24.MIAO J Q, CAI Y C, ZHANG Y K, et al.Study on the effect of lauryl arginine ethyl ester-chitosan coating on preserving freshness of cherries and its mechanism[J].Food and Fermentation Science &Technology, 2022, 58(5):19-24.
[16] LOTOS E D, MIHAI M, VASILIU A L, et al.Zein/polysaccharide nanoscale electrostatic complexes:Preparation, drug encapsulation and antibacterial properties[J].Nanomaterials, 2024, 14(2):197.
[17] 张智, 周楠, 冯丽荣, 等.内源乳化法制备青春双歧杆菌微胶囊[J].现代食品科技, 2023, 39(6):171-179.ZHANG Z, ZHOU N, FENG L R, et al.Preparation of Bifidobacterium adolescentis microcapsules by endogenous emulsification[J].Modern Food Science and Technology, 2023, 39(6):171-179.
[18] 陈敬鑫, 杨明亮, 葛永红, 等.海藻酸钠可食性膜及其食品保鲜应用的研究进展[J].渤海大学学报(自然科学版), 2021, 42(2):102-110.CHEN J X, YANG M L, GE Y H, et al.Research progress of sodium alginate-based edible films and their food preservation application[J].Journal of Bohai University (Natural Science Edition), 2021, 42(2):102-110.
[19] LIU Q, LI Y, HAN R, et al.Sodium alginate/gelatin hydrogel spheres loaded with Fructus Ligustri Lucidi essential oil:Preparation, characterization and biological activity[J].International Journal of Biological Macromolecules, 2024, 272:132726.
[20] 张讯. 海藻酸钠-玉米醇溶蛋白核壳微胶囊的制备、表征及应用研究[D].武汉:湖北工业大学, 2021.ZHANG X.Preparation, characterization and application of sodium alginate-zein core-shell microcapsules[D].Wuhan:Hubei University of Technology, 2021.
[21] JING H J, HUANG X, DU X J, et al.Facile synthesis of pH-responsive sodium alginate/carboxymethyl chitosan hydrogel beads promoted by hydrogen bond[J].Carbohydrate Polymers, 2022, 278:118993.
[22] 王牌. 琼胶/海藻酸钠复合膜的制备及在牛肉保鲜中的应用[D].上海:上海海洋大学, 2024.WANG P.Preparation of agar/sodium alginate composite membrane and its application in beef preservation[D].Shanghai:Shanghai Ocean University, 2024.
[23] 苏春儒. 玉米醇溶蛋白/多糖复合凝聚型包埋体系的构建及其应用研究[D].广州:广州大学, 2022.SU C R.Construction and application of zein/polysaccharide complex coacervative embedding system[D].Guangzhou:Guangzhou University, 2022.
[24] 翁玲, 张彦慧, 张若宁, 等.玉米醇溶蛋白-海藻酸钠纳米颗粒的制备及其负载姜黄素的研究[J].中国食品添加剂, 2024, 35(3):25-34.WENG L, ZHANG Y H, ZHANG R N, et al.Preparation of zein sodium alginate nanoparticles and their loading with curcumin[J].China Food Additives, 2024, 35(3):25-34.
[25] 郭希. 海藻酸钠可食用复合膜的制备及其在鲜切水果中的应用[D].杨凌:西北农林科技大学, 2021.GUO X.Preparation of sodium alginate edible composite film and its application in fresh-cut fruits[D].Yangling:Northwest A&F University, 2021.
[26] 卫赛超, 谢晶.复载纳他霉素的壳聚糖/玉米醇溶蛋白可食性涂膜对芒果低温保鲜效果的研究[J].热带作物学报, 2022, 43(9):1907-1917.WEI S C, XIE J.Effect of chitosan/zein edible coating compounded with natamycin on the low-temperature preservation of mango(Mangifera indica L.)[J].Chinese Journal of Tropical Crops, 2022, 43(9):1907-1917.
[27] 贾颜, 李茜, 李新艺, 等.含ACC脱氨酶的植物根际促生菌对月季切花品质与生理的影响[J].江苏农业科学, 2022, 50(16):147-153.JIA Y, LI Q, LI X Y, et al.Impacts of rhizosphere-promoting bacteria containing ACC deaminase on quality and physiology of cut rose flowers[J].Jiangsu Agricultural Sciences, 2022, 50(16):147-153.
[28] 陈佳妮, 罗耀华, 孔慧, 等.热激处理对鲜切百合鳞茎片贮藏品质的影响[J].食品科学, 2024, 45(9):163-172.CHEN J N, LUO Y H, KONG H, et al.Effect of heat shock treatment on the storage quality of fresh-cut lily bulbs[J].Food Science, 2024, 45(9):163-172.
[29] 梁仕茹, 蒙馨怡, 黄心怡, 等.基于玉米醇溶蛋白(zein)-海藻酸钠构建木犀草素输送体系及果蔬保鲜研究[J].食品安全导刊, 2024(13):129-134.LIANG S R, MENG X Y, HUANG X Y, et al.Construction of luteolin delivery system and preservation of fruits and vegetables based on zein (zein)-sodium alginate[J].China Food Safety Magazine, 2024(13):129-134.